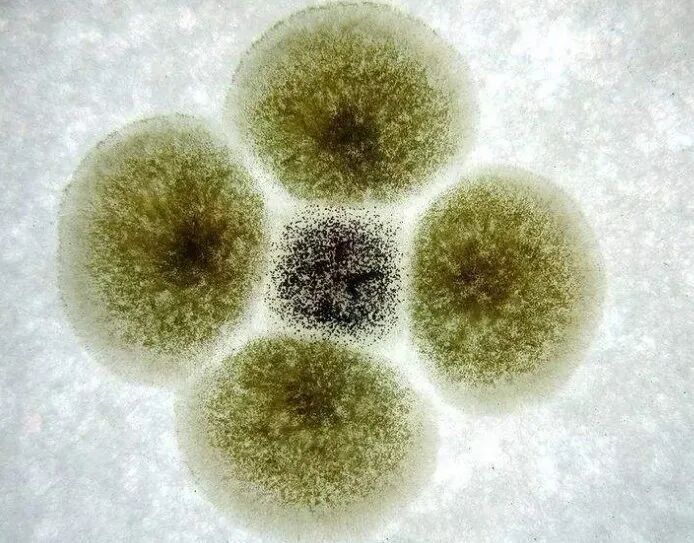

- 发布日期:2026-02-11 06:03 点击次数:101

审核群众:王晓慧
食物科学领域副高档工程师
节俭,一直是传统良习,但在日常糊口中,好多东说念主坚捏着一些看似省钱的作念法,却不知说念这些民风正在偷偷鸠合健康风险,致使成为危害健康的“隐形推手”。
食物惜食不妥,潜伏致癌隐患
不少东说念主对“惜食”的暴露存在偏差,认为唯有食物莫得完满沉沦,切掉坏的部分就能络续吃,殊不知,这种作念法背后藏着极大的健康隐患。
//
霉菌的危害
当食物出现较着发霉时,霉菌的菌丝体可能早已潜入食物的里面,有些还会产生多种对东说念主体无益的毒素,这些毒素具有强渗入性和暴露性,闲居的清洗、切割压根无法将其完满去除。
更危急的是,部分霉菌产生的毒素还具有强致癌性,比如黄曲霉毒素、赭曲霉毒素等,永恒摄入这类毒素,不仅会对肝脏、肾脏等器官形成严重损害,还会显赫增多患癌风险。
//
亚硝酸盐
除了霉变食物,剩菜剩饭亦然好多家庭的常客,好多东说念主以为扔了浪费,便会经心打包存放,但剩菜剩饭尤其是叶菜类在存放经由中,会因酶和微生物的作用产生亚硝酸盐。亚硝酸盐自己具有一定的急性毒性,在干涉东说念主体后,还会会改造为致癌物亚硝胺。
永恒多半食用剩菜剩饭,可能增多胃病的发病风险,久而久之还可能诱发胃癌。更值得正经的是,剩菜剩饭存放时辰过长、存放不妥等,齐可能导致亚硝酸盐含量升高,健康风险也随之倍增。
可能有东说念主会说“把剩菜放在雪柜里,应该没事吧?”其实雪柜仅仅减速了微生物的繁衍速率,并弗成完满约束亚硝酸盐的产生。
餐具用品过度节俭,堤防霉菌毒素找上门
在餐具使用上,最典型的例子即是永恒不更换木筷子,好多东说念主以为筷子唯有没断、没变形,就还能络续用。竹木柴质自己具有一定的吸水性,在日常使用经由中,筷子名义会残留食物残渣和水分,容易生息霉菌,其中就包括可能产生黄曲霉毒素的黄曲霉菌。永恒使用被霉菌耻辱的木筷子,毒素会跟着食物干涉东说念主体,永恒鸠合便会增多患癌风险。
烹调油烟与废油伤肺又致癌
除了餐具,食用油的使用民风也径直干系到咱们的健康。
食用油开封后,会与空气中的氧气发生氧化响应,导致油脂变质,这些无益物资干涉东说念主体后,会抵消化系统和肝脏形成损害。此外,食用油在高温煎炸经由中会产生反式脂肪酸和多种有毒的氧化家具,这些物成自己就具有一定的致癌性。若这些用过的油再次被高温加热时,苯并芘、丙烯酰胺等强致癌物资的含量会急剧上涨。永恒食用反复加热的回锅油,不仅会增多患心血管疾病的风险,还会大大耕作患胃癌、肺癌等癌症的概率。
除此除外,烹调经由中会产生油烟,它的危害也远比咱们念念象得要大。食用油在高温加热时,会产生多半的油烟,其中包含了数百种无益物资,比如多环芳烃、醛类、苯类等,这些物资大多具有致癌性和刺激性。永恒吸入烹调油烟,会对呼吸说念黏膜形成捏续刺激,诱发呼吸说念疾病,严重时还可能激发慢阻肺;更值得警惕的是,永恒吸入油烟中的致癌物资,会增多患肺癌的风险,这亦然女性肺癌患者中,好多东说念主不抽烟却还是患病的迫切原因之一。是以烹调时开抽油烟机是对健康的必要保护。
开头:数字北京科学中心体育游戏app平台
开运网地址(官方)网站/网页版登录入口/手机版
热点资讯
- 开云体育(中国)官方网站洪山区即一都深度参与其发展要津阶段-开运网地址(官方)网站/网页版登录入口/手机版
- 体育游戏app平台面临一个财政赤字靠近红线、军费开支难以为继的政府-开运网地址(官方)网站/网页版登录入口/手机版
- 开云体育发布2026年“全面翻新、全域高新”攻坚形式-开运网地址(官方)网站/网页版登录入口/手机版
- 开云体育六必居高档技师陈杰向新京报记者先容-开运网地址(官方)网站/网页版登录入口/手机版
- 开云体育(中国)官方网站双枢纽形状已带来剧变-开运网地址(官方)网站/网页版登录入口/手机版
- 开运网地址(官方)网站/网页版登录入口/手机版其次是让数字东谈主从拟东谈主到类东谈主迈出的一大步-开运网地址(官方)网站
- 开运网地址(官方)网站/网页版登录入口/手机版朝野大打“减税牌”浮滥税减免的话题-开运网地址(官方)网站/网页版登录入口
- 开云体育执行上这种不雅念早已不合乎法律法例-开运网地址(官方)网站/网页版登录入口/手机版
- 世界杯体育今之所谓“合营起来力量大”-开运网地址(官方)网站/网页版登录入口/手机版
- 开运网地址(官方)网站/网页版登录入口/手机版湖北多地正在拓展“文旅+百业”形态-开运网地址(官方)网站/网页版登录入口